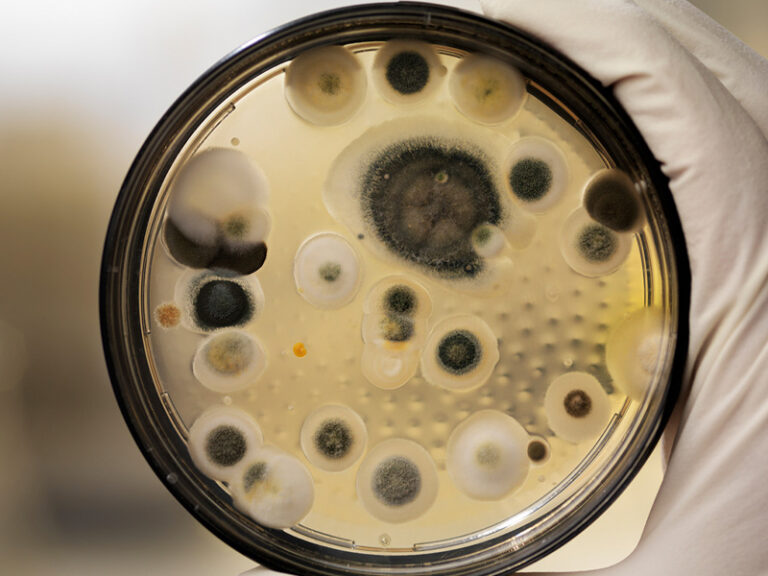

Build Your Ads/Posts
Download Imagery – Copy+Paste Text
Use for emails, social media posts, and more.
Imagery
Press Ctrl+C to copy, Ctrl+X to cut, or Ctrl+V to paste the image (Windows); or press ⌘+C, ⌘+X, or ⌘+V (Mac)
Titles
Press Ctrl+C to copy, Ctrl+X to cut, or Ctrl+V to paste the text (Windows); or press ⌘+C, ⌘+X, or ⌘+V (Mac)
Is Your Fridge Making You Sick?
The Easy-To-Use Spray Makes Your Food Stay Fresh
How To Stop Food Poisoning At Home
What’s Lurking In Your Fridge?
Got Mold In Your Fridge? Here’s How To Get Rid Of It For Good!
How To Keep Food Fresher, Longer
Here’s An Easy To Eat Healthier
Eat The Same Foods And Be Healthier
Body Copy
Press Ctrl+C to copy, Ctrl+X to cut, or Ctrl+V to paste the text (Windows); or press ⌘+C, ⌘+X, or ⌘+V (Mac)
FridgeGenie quickly sanitizes your refrigerator and protects it from new bacteria growth for up to 90 days.
There are two types of bacteria growing in your fridge. One degrades your food’s freshness; the other types can cause illness. Clean and protect your refrigerator with FridgeGenie.
According to the US Department of Agriculture (USDA), more than 1.8 million bacteria units live in the average home refrigerator. Clean and protect your refrigerator with FridgeGenie.
FridgeGenie creates a protective barrier that kills microbes on contact.
FridgeGenie invisible barrier defends against bacteria, germs, mold, & viruses for up to 90 days.
FridgeGenie’s sanitizes your refrigerator and protects it for up to 90 days.
FridgeGenie inhibits the growth of food-degrading bacteria, helping your food stay fresher for longer.
FridgeGenie uses all-natural ingredients to clean and protect your refrigerator for up to 90 days. It’s child-safe and pet-safe.
Some bacteria degrade your food prematurely, and others carry illnesses like Salmonella and Listeria. Protect your health with all-natural FridgeGenie.